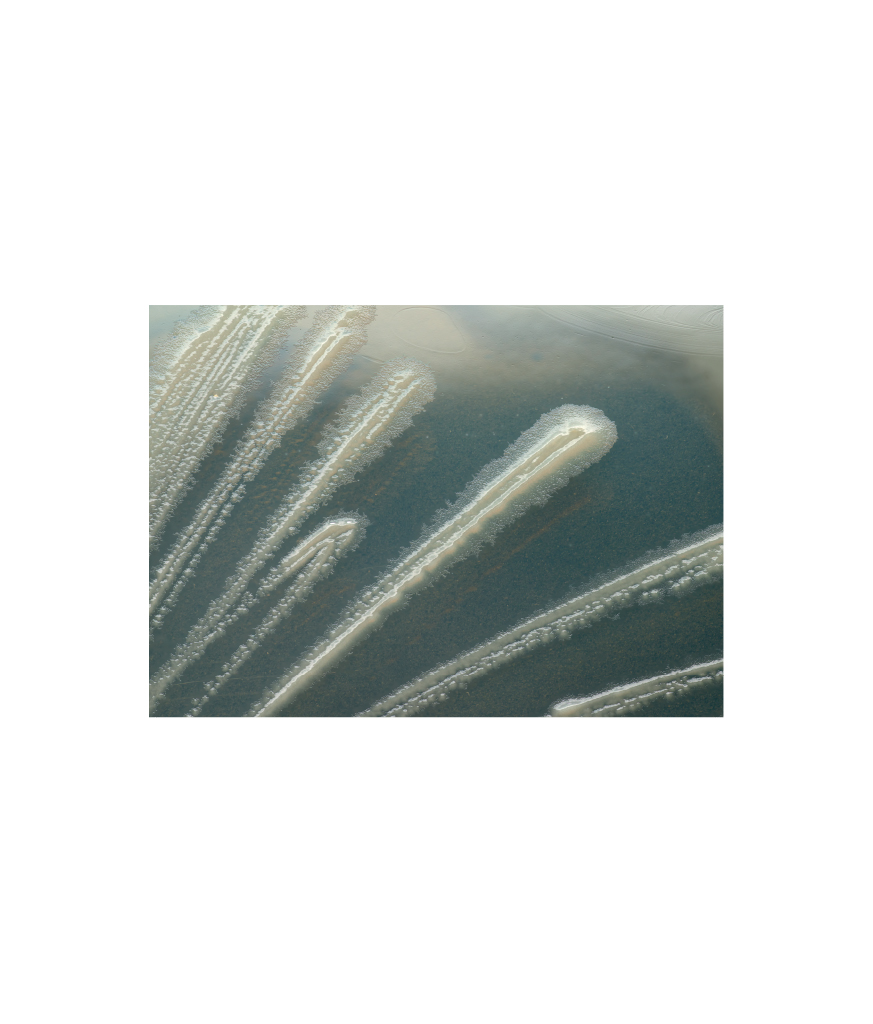

We use cookies to give you the best user experience. Your consent allows us to collect and process data about your interactions with the website. Some functions on the site are dependent on cookies, and will therefore not work as intended if you reject their use.
Functional cookies store information that makes the website's basic functions, such as navigation and login to secure areas of the website, possible. Without these, the website does not function optimally. Functional cookies store information about your preferences on the website. They are used to store settings for region and language, as well as visual elements.
The technical storage or access is necessary for the legitimate purpose of storing preferences that are not requested by the subscriber or user.
The technical storage or access that is used exclusively for statistical purposes.
Storage of statistical cookies, which are used exclusively for anonymous statistical purposes, based on the user's activity on the website. We use the information to improve the user experience and strengthen the effectiveness of the website. In addition, statistical information is used to display personalized content and prepare analyzes for the company's internal use.
Marketing cookies allow us to register your interests. We collect information about what content you see on the website, which ads you click on and what you buy. We use the information to show you ads that are targeted to your preferences.